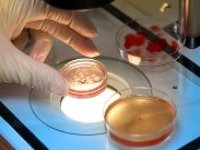

Kaan Bozkurt Hamile Kalanlar
çalıştığım yere yakın olduğu için 3 yıllık süreçte özel ege tüp bebek merkezinde görevli dr.
Kaan bozkurt hamile kalanlar. Ben pkoluyum 3 kez klomen bir negatif asilama bunlar istanbulda oldu sonra allah karsima kaan hocayi cikardi esimde sorun yoktu bu yuzden bizede tekrar asilama dedi ama ben istemedim direk tup olsun istedim yanliz benim surec biraz farkli isledi normalde 3 ayda bitecek olan tedavim 10 ayi buldu cunku ben cok uzaktan geliyodum her gittigimde bi islem yaptirdim en son yazin transfer icin gittim. Kaan beyle tanışmamız ablamin kaan beyin hastası olup güzel sonuç elde edilmesi ilgili doğru yönlendirme güler yüzü güven duygusu ile bana tavsiye edip gitmemle başladı her adımımız da yanımızda olması doğru yönlendirmelerle geçirdiğim operasyonlar da daha da kendisine güvenmem oraya her gittiğimde bütün çalışanların ve kaan beyin ailesinden biriymiş gibi. Canım dr kaan beyle görüşene kadar senden beterdim. Polikistik over sendromunun kadınlarda yarattığı en büyük problem adet düzensizliği adet olamama yumurtlama problemleri ve dolayısıyla gebe kalamamaktır.
Tanı ve tedavi için mutlaka doktorunuza başvurunuz. İzmir dr kaan bozkurt. Polikistik over olup kendiliğinden hamile kalanlar olduğu gibi polikistik over olup aşılama ile hamile kalanlar vardır. Bu 3 yıllık süreçte her ünvanda değişik bir sürü doktora gittim ve düşük sebeplerini araştırdım ve yaşım geçmekte olduğundan tüp bebek merkezlerini araştırdım.
Görüşmeden sonra anlayacaksın ne demek istediğimi. Site içeriği sadece bilgilendirme amaçlıdır. Kaan bozkurt 2020 tüm hakları saklıdır. Maliyet konusunda da elinden.
Bir başka önemli ayrıntı da hastanın kilosudur. Kaan bozkurt hocamın sayesinde eşimin doğum gününde hamile haberini aldık hocam önce allah sonra sizden binkere razıolsun inan engin tecrübeleriniz o güler yüzünüz sayesinde bizim hayatımıza mutluluk verdiniz herkese tavsiye ediyorum sabırla hocama kendinizi emanet edin göreceksiniz güzellikler sizlerle olacak kaan hocam adım. Benim gibi yumurta verimi azalmış bir sürü hasta ve gebe kalanlar görmem bir yana doktorumla görüşme sonrası bugüne kadar doğru dileklerde bulunmadığımı anladım. Azospermi tedavisi ile hamile kalanlar azospermi bebek sahibi olanlar günümüzde oldukça fazladır.
Kaan bozkurt 1995 1996 yıllarında hakkari yüksekova devlet hastanesi nde kadın hastalıkları ve doğum uzmanı ve başhekim olarak zorunlu hizmetini yerine getirmiştir. 1996 yılında hacettepe üniversitesi tıp fakültesi tüp bebek merkezi nde üremeye yardımcı tedavi.